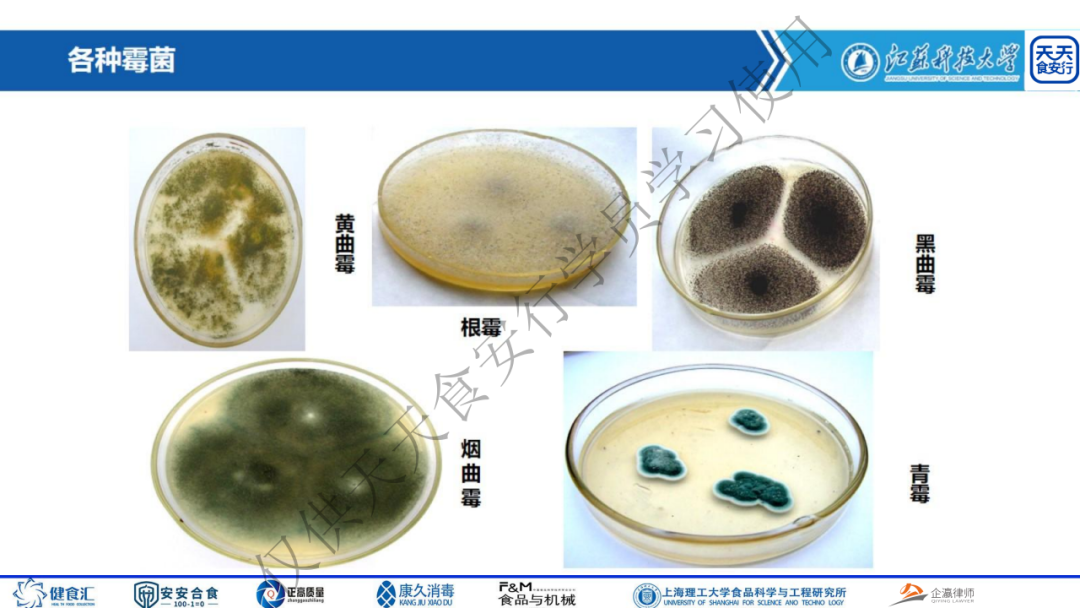
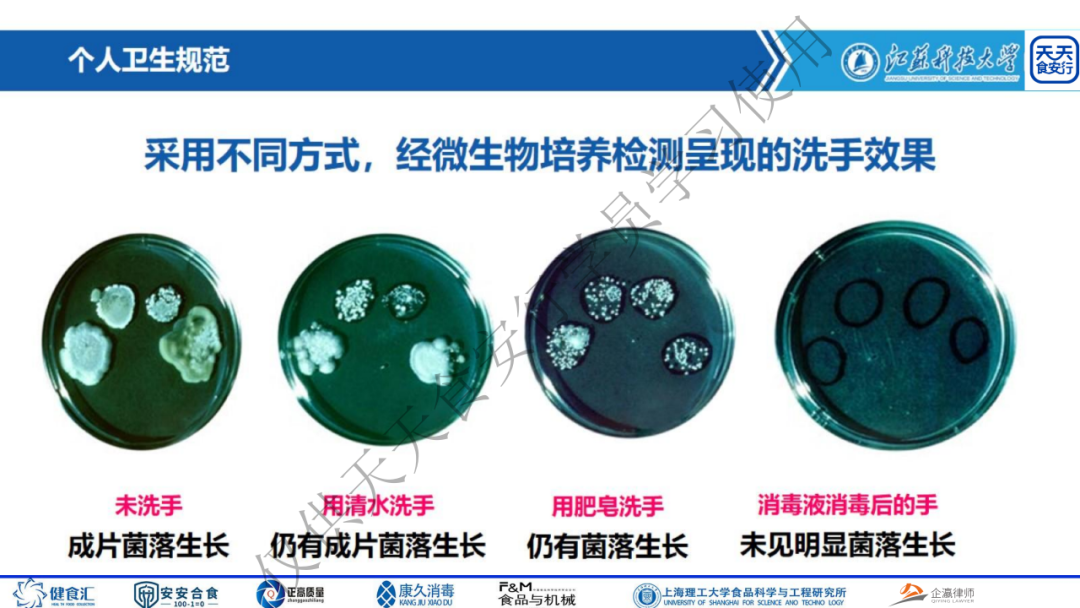

文章编辑:天天食安行
内容来源:原创

2023年05月30日下午14:00-15:00,天天食安行·公益大讲堂:江苏科技大学教授,食品质量与安全系主任,工学博士,硕士生导师,国家注册QMS及FSMS体系审核员,江苏省省级科技特派员郭元新教授给大家分享《浅谈食品企业质量意识的培养》

今日直播预告
2023年06月06日下午14:00-15:00,天天食安行·公益大讲堂:上海康久消毒技术有限公司创始人、食品工厂消毒规划与设计专家周立法先生,给大家直播分享《食品厂臭氧消毒设备的选择与应用》。点击下图长按“识别图中的二维码”,提前登记、预约直播课程。公益讲座,不收取任何费用。

